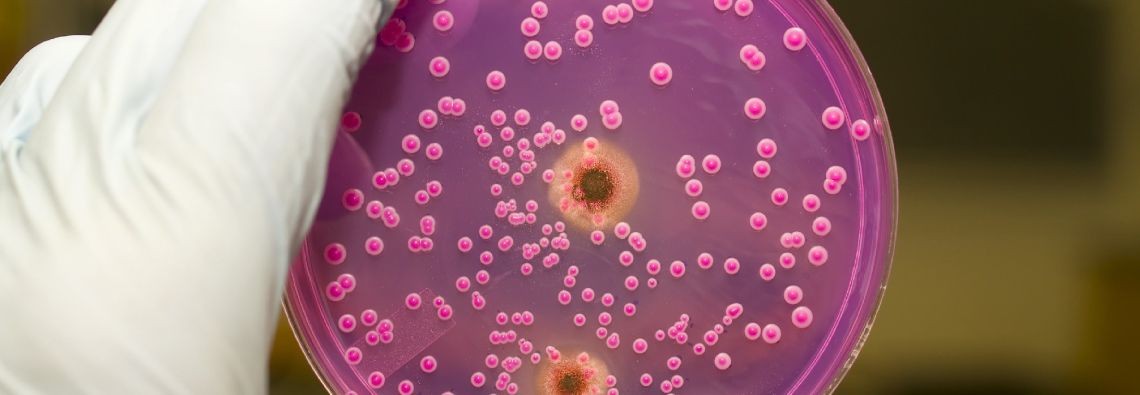

We Provide Quality Testing Service
TO ENSURE THE HEALTH AND SAFETY OF YOUR FAMILY OR BUSINESS. GET A FREE QUOTE ON OUR TESTING SERVICES.

About us
15+ Years Experience in Testing Service
With over 15+ years of experience CECL has been recognized as the leader within the Hazardous Materials Industry. Providing residential, commercial & industrial clients an expert service you can count on. Provided services include asbestos testing, hazmat reports, risk assessments, lead testing, mold testing, air quality testing, VOC testing, safety consulting. Stop work order consulting, WorkSafeBC compliance consulting, safety programs, worker training, air monitoring and much more!
Our Service Location Area
Vancouver, Burnaby, Richmond, Coquitlam, Port Coquitlam, Port Moody, Pitt Meadows, Maple Ridge, Mission, West Vancouver, North Vancouver, Squamish, Whistler, Surrey, Langley, Abbotsford, chilliwack, Hope.
Read more..
Our Services

Air quality testing detects harmful pollutants to protect health and meet regulations. It’s done indoors and outdoors using sensors to measure PM2.5, CO₂, VOCs, and other contaminants.
Mold testing identifies hidden mold growth to prevent health issues and property damage. It’s done in damp areas using air or surface sampling methods analyzed in a lab.

Lead testing detects toxic lead presence to prevent poisoning, especially in children. It's performed in paint, water, soil, or dust using kits or lab analysis, mainly in older buildings.

Asbestos testing identifies hazardous fibers that can cause serious lung diseases. It’s conducted in older buildings by collecting material or air samples, analyzed in specialized labs.

Hazmat surveying detects hazardous materials to ensure safety and legal compliance during projects. It’s done at sites like buildings or industrial areas using inspection, sampling, and lab testing.
Testimonial
What Clients Says
Articles




